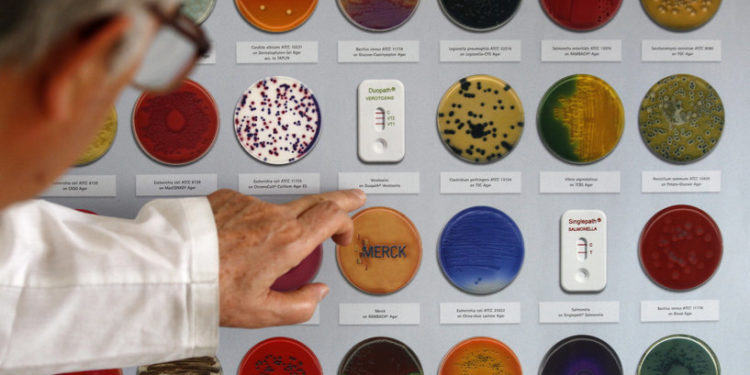
إصابات جديدة بالـ”بكتيريا القولونية” في أميركا

حرية – (28/8/2022)
قالت المراكز الأميركية لمكافحة الأمراض والوقاية منها، الخميس، إن تفشي “البكتيريا الإشريكية القولونية” في أربع ولايات بالغرب الأوسط من مصدر غير معروف، أثر على 47 شخصا آخرين، مما رفع العدد الإجمالي إلى 84 شخصا.
وحتى يوم الأربعاء، تم نقل 38 شخصا إلى المستشفى. ورغم أن العديد من سلالات البكتيريا الإشريكية القولونية توجد في أمعاء الأشخاص والحيوانات الأصحاء وهي غير ضارة، فإن أنواعا معينة يمكن أن تسبب تقلصات شديدة في الأمعاء وإسهالا دمويا وقيئ.
وقالت المراكز إنه من بين 62 شخصا قابلتهم، تبين أن 52 تناولوا الطعام في مطاعم “وينديز” في الأسبوع السابق لبدء مرضهم.
وقالت سلسلة مطاعم البرغر لرويترز في رسالة بالبريد الإلكتروني “نتعاون بشكل كامل مع سلطات الصحة العامة في تحقيقاتها الجارية بشأن تفشي الإشريكية القولونية على المستوى المحلي”.
وتمثل الحالات الجديدة زيادة عن يوم الجمعة الماضي، عندما بدأت المراكز الأميركية تحقيقا بعد إصابة 37 شخصا في جميع أنحاء ميشيغان وأوهايو وإنديانا وبنسلفانيا.